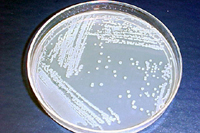

Mancha aquosa das cucurbitáceas
Acidovorax avenae subsp. citrulli (= Pseudomonas pseudoalcaligenes subsp. citrulli, Pseudomonas avenae subsp. citrulli)melancia, melão (cantaloupe, honeydew), pepino, abóbora, abobrinha, cabaça, melancia forrageira (melancia do mato, melancia de cavalo ou melancia de porco) e outras cucurbitáceas

Fruto maduro de melancia com sintomas típicos de mancha aquosa, tais como lesões encharcadas (manhas oleosas, pt) de forma irregular com rachaduras.
Sintomas e sinais
A mancha aquosa afeta a folhagem em todos os estádios de crescimento e os frutos de uma ampla gama de cucurbitáceas. Os sintomas podem ser inicialmente observados nas plântulas entre cinco e oito dias após o plantio, dependendo das condições ambientais. Na maioria das cucurbitáceas, os sintomas iniciais nas plântulas incluem o aspecto encharcado da face abaxial dos cotilédones (Figura 2). Elevada humidade relativa nas primeiras horas da manhã pode levar a uma congestão aquosa natural nos cotilédones, o que pode assemelhar-se aos sintomas da mancha aquosa. No entanto, diferente da congestão aquosa natural, as lesões associadas com a mancha aquosa têm uma aparência oleosa e persistem sob condições secas, e, portanto, são observáveis após o meio-dia (Figura 3). As lesões encharcadas (manhas oleosas, pt) começam como manchas individualizadas, mas, com o desenvolvimento da doença, elas coalescem e estendem-se ao longo dos vasos dos cotilédones. As lesões podem estender-se ao longo dos caules até aos tecidos das folhas verdadeiras e, em casos severos, determinam o colapso e morte das plântulas de forma semelhante ao "damping-off" (tombamento, br; murchidão das plântulas, pt). Eventualmente, as manchas encharcadas (manhas oleosas, pt) secam formando lesões alongadas, escuras a castanho-avermelhadas que se desenvolvem sobre e ao longo dos vasos cotiledonares (Figura 4). Sintomas semelhantes ocorrem em melão (Figura 5) e em plântulas de outras cucurbitáceas.

Figura 2 |

Figura 3 |

Figura 4 |

Figura 5 |
Em folhas maduras de melancia, lesões individualizadas escuras a castanho-avermelhadas desenvolvem-se ao longo dos vasos, no entanto, podem ser imperceptíveis e difíceis de distinguir dos sintomas de outras doenças foliares (ex. antracnose e crestamento gomoso (gomose, pt) do caule). Em folhas de cantaloupe, os sintomas incluem lesões castanho claras a castanho-avermelhadas ao longo dos vasos das folhas (Figura 6), mas também incluem lesões em forma de V que se estendem desde a margem até à base da folha (Figura 7). Os sintomas de mancha aquosa na folhagem de abóbora incluem também lesões castanho claras ao longo dos vasos das folhas (Figura 8), mas clorose extensiva pode estar presente (Figura 9). Apesar dos sintomas incluirem manchas foliares, estas podem ser imperceptíveis e o seu efeito ser pequeno ou nulo na planta hospedeira. As perdas econômicas são consequência da fase correspondente à podridão dos frutos.

Figura 6 |

Figura 7 |

Figura 8 |

Figura 9 |
Os sintomas de mancha aquosa nos frutos de melancia aparecem imediatamente antes da maturidade de colheita como pequenas manchas (< de 1 milímetro de diâmetro) na superfície superior do fruto, de formato irregular e de cor verde oliva (Figura 10). Estas lesões, embora pequenas inicialmente, podem espalhar-se e cobrir toda a superfície superior do fruto. Nas etapas iniciais de infecção estas lesões são firmes e raramente penetram na polpa do fruto. Rachaduras castanhas podem desenvolver-se nas lesões da casca e podem libertar exsudatos bacterianos efervescentes de cor âmbar-amarelo (Figuras 11 e 12). Em etapas avançadas, os frutos colapsam apresentando uma podridão aquosa devido à invasão de organismos colonizadores secundários (Figura 13). Os sintomas de mancha aquosa nos frutos de melão começam também como manchas individualizadas verdes escuras (Figura 14); no entanto, com o amadurecimento do fruto, as lesões convertem-se em pequenas depressões na casca (Figuras 15 e 16). Em melões com casca rendilhada (ex. cantaloupe), o rendilhado não se desenvolve sobre as áreas necróticas, resultando em manchas lisas afundadas (Figura 17). As lesões do melão não se estendem sobre a superfície dos frutos, mas penetram através do pericarpo (parede do fruto) causando cavidades apodrecidas de cor castanha (Figura 18). Sintomas similares ocorrem em abóbora incluindo lesões encharcadas (manhas oleosas, pt) com rachaduras na casca (Figura 19) e podridão interna do fruto (Figura 20).

Figura 10 |

Figura 11 |

Figura 12 |

Figura 13 |

Figura 14 |

Figura 15 |

Figura 16 |

Figura 17 |

Figura 18 |

Figura 19 |

Figura 20 |
Biologia do patógeno (agente patogénico, patogénio, pt)
Acidovorax avenae subsp. citrulli é uma bactéria gram-negativa, com formato de bastonete e dimensões médias de 0,5 x 1,7 µm, móvel por um único flagelo polar. A bactéria é estritamente aeróbica, com atividade oxidase positiva e cresce a 41º C (106º F) mas não a 4º C (39º F). A. avenae subsp. citrulli cresce na maioria dos meios de cultura gerais para bactérias e forma colônias lisas, redondas, cor creme e não fluorescentes após 48 h em meio B de King (Figura 21). Usando características fisiológicas, o patógeno (patogénio, pt) foi inicialmente classificado como membro do grupo III do gênero Pseudomonas e identificado como Pseudomonas pseudoalcaligenes subsp. citrulli. Baseados em dados de hibridização do ácido nucleico, análise de proteína total da célula e perfis de utilização de substratos de carbono, o patógeno (patogénio, pt) foi reclassificado como A. avenae subsp. citrulli.
Figura 21 |
Originalmente, foi reportado que A. avenae subsp. citrulli causava requeima e lesões nas plântulas de melancia, mas não podridão do fruto. Adicionalmente, a estirpe original recuperada de introduções de plantas na Estação Experimental de Agricultura na Georgia (GA) não induziu resposta de hipersensibilidade (HR) em folhas de fumo (tabaco, pt). No entanto, estirpes recuperadas a partir dos primeiros surtos de mancha aquosa em campos comerciais de melancia em 1989 tiveram reação positiva no teste de HR (5) e causaram severa podridão do fruto. Esta discrepância causou confusão sobre a identidade do agente causal da mancha aquosa. No entanto, baseado em análises de ácidos graxos (ácidos gordos, pt), dados de fingerprinting de DNA (Figura 22) e de utilização de substratos de carbono, foi demonstrado que existiam pelo menos dois subgrupos diferentes do patógeno. Em geral, estirpes do grupo II são muito agressivas em melancia, medianamente agressivas noutras cucurbitáceas e inclui as estirpes que causaram os primeiros surtos de mancha aquosa em campos comerciais. Por outro lado, as estirpes do grupo I são pouco a moderadamente agressivas numa ampla gama de cucurbitáceas hospedeiras e inclui as estirpes que causavam requeima de plântulas de melancia nas introduções da Estação Experimental de Agricultura na Georgia. Esta estirpe poderia ter reduzido a agressividade por mutação ou poderia representar uma subpopulação geneticamente diferente. Atualmente, ainda se desconhece muito acerca da biologia de A. avenae subsp. citrulli.

Figura 22 |
Ciclo da doença e epidemiologia

O inóculo presente na semente é a fonte de inóculo primário mais importante para o desenvolvimento epidêmico da mancha aquosa. As sementes da maioria das cucurbitáceas podem transmitir a mancha aquosa através de semente infestada. Infelizmente, conhece-se muito pouco acerca da biologia da infestação de sementes de cucurbitáceas por A. avenae subsp. citrulli. Adicionalmente, não se sabe se o patógeno (patogénio, pt) sobrevive acima ou abaixo do tegumento da semente. As sementes dentro de frutos infectados tornam-se infestadas por contato com tecidos contaminados, no entanto, na produção comercial de sementes, realiza-se a inspeção dos campos e somente frutos sem sintomas são usados. Por isso, a importância da semente infestada produzida em frutos sintomáticos é questionável. Recentemente, foi descoberto que a colonização de flores femininas de melancia poderia causar a infestação da semente por A. avenae subsp. citrulli apesar dos sintomas de mancha aquosa não se desenvolverem no fruto. Este mecanismo de infestação de semente pode possivelmente explicar a produção de lotes de semente contaminada provenientes de campos inspecionados visualmente. Apesar destas descobertas, o significado epidemiológico da colonização floral na infestação de semente deve ser determinado. Embora seja claro que a semente infestada é importante para os surtos de mancha aquosa, existem outras fontes possíveis de inóculo que incluem plântulas voluntárias, plantas daninhas da família cucurbitácea e resíduos infectados em apodrecimento.
O plantio de semente infestada resulta na transmissão da mancha aquosa para as plântulas sob condições ambientais ideais. A transmissão da mancha aquosa para as plântulas é muito dependente da ocorrência de humidade relativa elevada, por isso o risco de surtos da doença é reduzido com a sementeira direta. De forma crescente, a produção comercial de cucurbitáceas envolve o transplantio de plântulas produzidas em estufa para o campo para garantir um rápido estabelecimento do estande (povoamento, pt) no campo. As condições da estufa com temperaturas altas, humidade relativa elevada e grandes densidades de plântulas são conducivas à transmissão da mancha aquosa para as plântulas e à rápida dispersão da doença (Figura 23). O mecanismo exato da transmissão da mancha aquosa para as plântulas é desconhecido mas as bactérias movimentam-se desde a semente para os tecidos da plântula onde se multiplicam.
As bactérias dispersas por respingos de água iniciam infecções secundárias que são responsáveis pelo desenvolvimento rápido de epidemias e pelo alto número de plântulas infectadas. Na ausência de sintomas, populações epifíticas de A. avenae subsp. citrulli podem iniciar surtos de mancha aquosa em condições favoráveis de campo. Por causa desses fatores, o risco de desenvolvimento da mancha aquosa é elevado, mesmo para lotes de sementes com níveis baixos de contaminação.

Figura 23 |
Em condições de campo, humidade relativa elevada e alta temperatura favorecem o desenvolvimento da mancha aquosa. A. avenae subsp. citrulli é disseminada por chuva associada a vento bem como pela água de irrigação, e causa lesões foliares e sintomas de requeima. Usualmente, as plantas infectadas não morrem pela infecção, e, na maioria dos casos, os sintomas na folhagem da planta adulta são difíceis de reconhecer. Lesões foliares e populações epifíticas servem como reservatórios de inóculo de A. avenae subsp. citrulli e contribuem para as infecções secundárias. A bactéria penetra nas folhas pelos estomas e ferimentos e permanece no apoplasto (espaços intercelulares) dos tecidos infectados (Figura 24). Não existe evidência de migração bacteriana sistêmica através da planta. No caso da infecção do fruto, a bactéria depositada na casca do fruto duas ou três semanas após antese (florescimento) entra através dos estomas para iniciar a infecção. Após esse período, os estômatos (estomas, pt) são bloqueados pela deposição de ceras na superfície do fruto que impedem invasões posteriores. Dessa forma, geralmente os frutos maduros não são naturalmente suscetíveis a infecções de A. avenae subsp. citrulli, a menos que ocorram ferimentos.

Figura 24 |
Durante as primeiras etapas de desenvolvimento do fruto, os sintomas da mancha aquosa não são evidentes ou estão ausentes, mas aparecem rapidamente quando os frutos alcançam a maturidade de colheita ou imediatamente antes disso. Lesões superficiais expandem-se rapidamente e, eventualmente, os frutos podem apodrecer no campo. A avenae subsp. citrulli pode sobreviver no inverno nos restos da casca do fruto ou em sementes infestadas que podem produzir plantas voluntárias nas culturas subsequentes.
Manejo da doença (controle, pt)
Devido à ausência de cultivares comerciais resistentes, o manejo (controle, pt) bem-sucedido da mancha aquosa depende da exclusão do inóculo primário, das práticas culturais e do uso de bactericidas cúpricos. Atualmente, não existe nenhuma medida única de controle eficiente para o manejo (controle, pt) da mancha aquosa já que a eficácia do controle químico depende das condições ambientais. Adicionalmente, o manejo (controle, pt) eficiente da doença deve-se focar na produção de sementes e mudas (plântulas, pt).
Manejo (controle, pt) da mancha aquosa em campos de produção de sementes
A estratégia de manejo (controle, pt) mais importante para a mancha aquosa é a exclusão de A. avenae subsp. citrulli através do uso de sementes e mudas (plântulas, pt) livres do patógeno (patogénio, pt). É impossível garantir uma semente livre do patógeno (patogénio, pt), mas a realização de testes de sanidade da semente reduz o risco de surtos. Atualmente, o teste de semente padrão para mancha aquosa é o teste de crescimento de plântulas (Figura 25) no qual 10.000-30.000 sementes por lote são semeadas em condições conducivas ao desenvolvimento da mancha aquosa. As plântulas são visualmente inspecionadas para detecção de sintomas de mancha aquosa após 18 dias.

Figura 25 |
Para reduzir o risco de infestação da semente, as sementes de cucurbitáceas são produzidas em regiões de clima frio e seco de países sem histórico de mancha aquosa (Figura 26), empregando rotações de 3 a 5 anos com culturas que não pertençam à família das cucurbitáceas. Os campos de semente são inspecionados visualmente, e somente é usada a semente proveniente de campos livres de mancha aquosa.

Figura 26 |
Atualmente, nenhum tratamento da semente, quer seja químico ou físico, é 100% efetivo na erradicação de A. avenae subsp. citrulli. Embora os tratamentos de sementes como termoterapia, NaOCl, fermentação, HCl e ácido peroxiacético reduzam significativamente a transmissão da mancha aquosa para as plântulas, podem afetar negativamente a fisiologia da semente. Existem dois fatores que influenciam a eficiência do tratamento de sementes: 1) a incapacidade dos tratamentos penetrarem no tegumento da semente e 2) a localização da bactéria sobre ou no interior da semente. Devido ao risco de desenvolvimento da mancha aquosa nas instalações de produção de mudas (plântulas, pt) ser alto para sementes com níveis baixos de infestação, o tratamento apenas das sementes não controla a mancha aquosa.
Manejo (controle, pt) da mancha aquosa em instalações de produção de mudas (plântulas, pt) de plantas
Para evitar a introdução de A. avenae subsp. citrulli em estufas com mudas (plântulas, pt), deve utilizar-se somente semente testada e livre do patógeno (patogénio, pt). Para minimizar a dispersão secundária do patógeno (patogénio, pt), o contato físico com as plântulas deve ser mantido ao mínimo e devem ser usadas bandejas de mudas (plântulas, pt), esterilizadas para minimizar o risco de contaminação a partir do cultivo anterior. Fertilização e programas de controle de pragas adequados devem ser implementados para promover um crescimento saudável das mudas (plântulas, pt).
Para prevenir a dispersão do patógeno (patogénio, pt), o tráfego e o movimento de equipamentos e maquinaria entre estufas deve ser minimizado. Idealmente, as sementes provenientes de lotes diferentes deveriam ser plantadas em estufas diferentes. No entanto, como usualmente isso não é praticável, deveriam utilizar-se barreiras plásticas de 60 cm (24 pol.) de altura entre as mudas (plântulas, pt) (Figura 27). Se possível, deveria usar-se irrigação do tipo inundação subsuperficial ("ebb and flow") em vez de irrigação por aspersão para reduzir a dispersão de A. avenae subsp. citrulli por respingos de água. No entanto, isso tem um custo proibitivo e raramente é implementado. Com irrigação por aspersão, a rega deveria ser realizada ao meio-dia para facilitar a rápida secagem da superfície da planta e a pressão de saída da água deveria ser baixa para evitar a formação de aerossóis.

Figura 27 |
Para facilitar a detecção precoce de surtos de mancha bacteriana, rotineiramente realizam-se inspeções visuais das plântulas. Como é possível que A. avenae subsp. citrulli sobreviva epifiticamente sobre plântulas assintomáticas, todas as mudas (plântulas, pt) produzidas em estufa com mancha aquosa devem ser descartadas. Esta é uma opção muito cara já que o plantio deverá atrasar-se e a janela de mercado alvo será perdida. Assim, em casos onde é impossível economicamente descartar as plântulas expostas, as mudas (plântulas, pt) sintomáticas e as vizinhas devem ser descartadas. As plântulas remanescentes devem ser tratadas com bactericidas à base de cobre. Adicionalmente, a humidade relativa nas instalações de produção de mudas (plântulas, pt) deve ser reduzida aumentando o fluxo de ar e devem implementar-se no campo programas agressivos de manejo (controle, pt) da mancha aquosa baseados em bactericidas cúpricos. Após cada ciclo de produção de mudas (plântulas, pt), as estufas devem ser desinfetadas completamente e esvaziadas por pelo menos dois ou três semanas antes do plantio com cucurbitáceas.
Manejo (controle, pt) da mancha aquosa em campos de produção de frutos
Não existem cultivares de cucurbitáceas comerciais com imunidade à mancha aquosa. Embora várias introduções de melancia serem resistentes, todos as cultivares comerciais são suscetíveis à doença. Para excluir a bactéria dos campos comerciais de produção de frutos, devem usar-se sementes testadas e plântulas livres de mancha aquosa. Devem realizar-se rotações de três anos de duração com culturas que não pertençam à família das cucurbitáceas. Os restos culturais, tais como frutos de melancia de refugo provenientes de campos com mancha aquosa, devem ser enterrados profundamente no fim de cada estação de crescimento. Cultivos subsequentes de cucurbitáceas devem ser estabelecidos em campos novos, fisicamente separados do local do surto. Se possível, hospedeiros alternativos, tais como cucurbitáceas selvagens e voluntárias, devem ser eliminados das regiões ao redor dos campos de produção e das instalações de produção de mudas (plântulas, pt).
Para manejo (controle, pt) preventivo, aplicações com bactericidas à base de cobre tais como hidróxido de cobre, hidroxisulfato de cobre ou oxicloreto de cobre devem ser empregados quinzenalmente na dose recomendada ou semanalmente usando metade da dose recomendada. Pulverizações preventivas devem iniciar-se antes ou durante a antese (florescimento) e continuar até ao amadurecimento dos frutos. Se os sintomas de mancha aquosa se continuarem a desenvolver, devem realizar-se aplicações semanais de bactericidas à base de cobre na dose recomendada. Para prevenir a dispersão, deve evitar-se os tratos (atividades, pt) culturais nos campos com mancha aquosa quando a folhagem está molhada e o equipamento de campo deve ser desinfetado antes de levá-lo para outro campo.
Importância
A mancha aquosa pode causar perdas econômicas significativas na produção de cucurbitáceas, e tem sido responsável por mais de 90% das perdas de rendimento comercial nalguns campos de produção de melancia. A mancha aquosa foi observada pela primeira vez em melancia em 1965 na estação de introduções de plantas do Departamento de Agricultura dos Estados Unidos (USDA) em Griffin, GA, causando sintomas de requeima de plântulas. A doença ficou confinada às mudas (plântulas, pt) da estação, o que sugere que foi introduzida a partir de sementes das plantas introduzidas. Além disso, não houve surtos em campos comerciais de melancia durante esse período. Por 1988, surtos de mancha aquosa foram observados em campos comerciais de melancia nas Ilhas Mariana (no norte do Oceano Pacífico). Em 1989, o primeiro surto no território continental dos Estados Unidos foi observado na Florida. Parece agora claro que a fonte de inóculo nas melancias comerciais foi independente do surto de requeima de plântulas ocorrido na Estação de Introduções de Plantas do USDA em GA. Desde 1989, os surtos de mancha aquosa têm ocorrido esporadicamente nos maiores estados produtores de cucurbitáceas nos Estados Unidos causando impacto econômico significativo. Notavelmente, a mancha aquosa causou perdas importantes em 1994 quando, devido à sobrevivência do patógeno (patogénio, pt) na semente, aliado à falta de testes de sanidade de semente adequados, deu origem a surtos epidêmicos de grande extensão na Florida, Georgia, Indiana, Carolina do Sul e Texas. Estes surtos provocaram a atenção nacional para a mancha aquosa e ressaltaram a ameaça apresentada pelas doenças transmitidas por semente. As repercussões destes surtos incluíram perdas econômicas diretas, assim como processos legais caros contra produtores de sementes e mudas (plântulas, pt). A magnitude econômica desses processos legais forçaram algumas empresas de sementes a sair do mercado enquanto outras suspenderam o comércio de semente de melancia nalguns estados que apresentavam alto risco de incidência da doença. Inclusive hoje, alguns produtores de semente não garantem a qualidade da sua semente na Carolina do Sul por medo de sofrer processos legais. Afortunadamente, com a implementação de testes de sanidade de semente rotineiros, muitas empresas reiniciaram a venda de semente de melancia com risco reduzido de transmissão da mancha aquosa. Apesar da implementação de testes de sanidade de semente rotineiros, surtos de mancha aquosa continuam a ocorrer e, no ano 2000 e 2001, importantes surtos epidêmicos ocorreram nos Estados Unidos. Adicionalmente, surtos têm ocorrido numa ampla gama de cucurbitáceas na Austrália, Brasil, China, Costa Rica, Israel, Japão, Nicarágua, Taiwan e Tailândia.
Esta ampla distribuição geográfica indica que a semente é ainda uma fonte importante de inóculo para a mancha aquosa e sugere a necessidade de melhorar as estratégias de manejo (controle, pt).
Para se resguardar dos processos legais, os produtores de semente atualmente incluem um termo de responsabilidade em cada pacote de semente de melancia, declarando que embora a semente tenha sido testada, não há garantia de que estejam livres de A. avenae subsp. citrulli. Adicionalmente, no momento da compra, é pedido aos agricultores para renunciar aos seus direitos [exemplo de um acordo de compra de semente de melancia (Figura 28)] de iniciar ações legais contra os produtores de semente no caso de acontecer um surto de mancha aquosa.
Referências Selecionadas
Hopkins, D., C. Thompson, J. Hilgren, and B. Lovic. 2001. Wet seed treatment with peroxyacetic acid for the control of bacterial fruit blotch and other seedborne diseases of watermelon . Plant Dis. 87:1495-1499
Hopkins, D. L. and C.M. Thompson. 2002. Seed transmission of Acidovorax avenae subsp citrulli in cucurbits. Hortscience 37:924-926.
Latin, R. X. and D.L. Hopkins. 1995. Bacterial fruit blotch of watermelon: The hypothetical exam question becomes reality. Plant Dis. 79:761-765.
Schaad, N. W., G. Sowell, R.W. Goth, R. R. Colwell, and R.E. Webb. 1978. Pseudomonas pseudoalcaligenes subsp. citrulli subsp. nov. Int. J. Syst. Bact. 28:117-125.
Somodi, G. C., J.B. Jones, D.L. Hopkins, R.E. Stall, T.A. Kucharek, N.C. Hodge, and J.C. Watterson. 1991. Occurrence of a bacterial watermelon fruit blotch in Florida. Plant Dis. 75:1053-1056.
Walcott, R. R., A. Fessehaie, and A.C. Castro. 2004. Differences in pathogenicity between two genetically distinct groups of Acidovorax avenae subsp. citrulli on cucurbit hosts. J. Phytopathology 152:277-285.
Webb, R. E. and R.W. Goth. 1965. A seedborne bacterium isolated from watermelon. Plant Dis. Rep. 49:818-821.
Willems, A., M. Goor, S. Thielemans, M. Gillis, K. Kersters, and J. DeLey. 1992. Transfer of several phytopathogenic Pseudomonas species to Acidovorax as Acidovorax avenae subsp. avenae subsp. nov., comb. nov., Acidovorax avenae subsp. citrulli, Acidovorax avenae subsp. cattleyae, and Acidovorax konjaci. Int. J. Syst. Bact. 42:107-119
